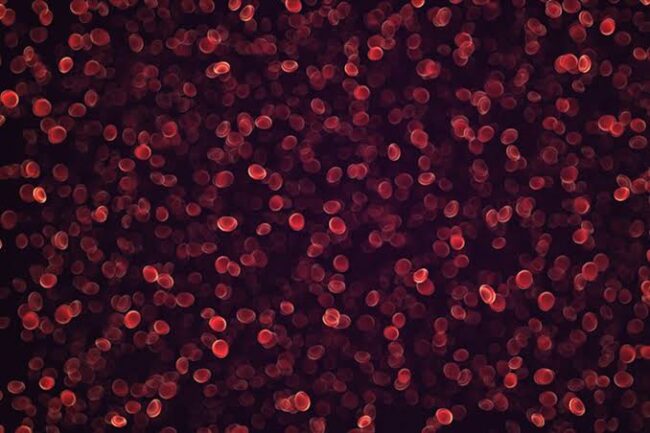
oscabecasdanoticia-image.jpeg

Nudez de ator em nu frontal choca e repercute nas redes sociais
A nova série da Netflix, Sex/Life, está dando o que falar. Até mesmo quem ainda não é espectador do show foi surpreendido com os comentários da cena de nudez frontal do personagem Brad, interpretado por Adam Demos. Isso porque, a cena que revela o porte físico do ator, e o tamanho do “documento” enlouqueceu os…